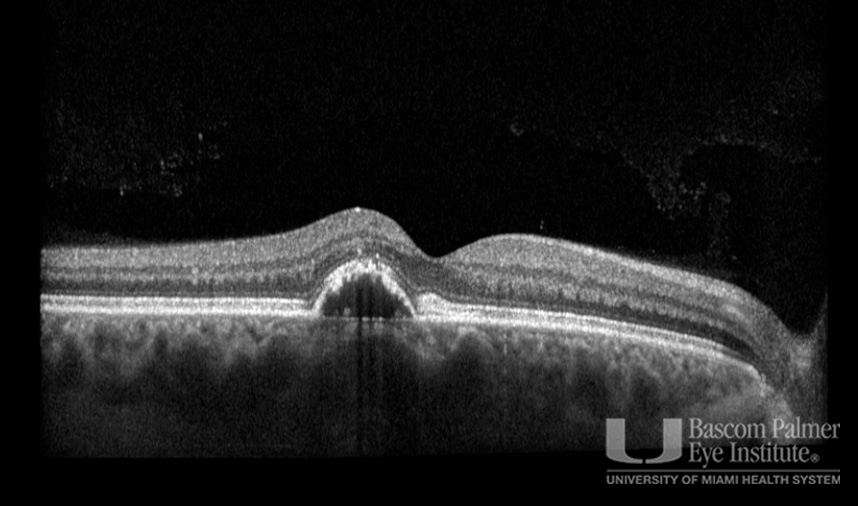
Macular Choroidal Neovascularization (CNV) Secondary to Punctate Inner Choroiditis
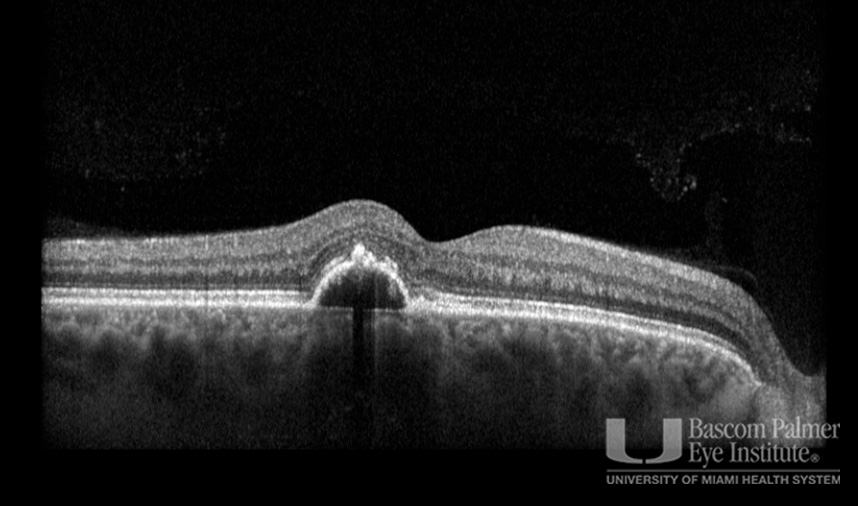
Macular Choroidal Neovascularization (CNV) Secondary to Punctate Inner Choroiditis

Macular Choroidal Neovascularization (CNV) Secondary to Punctate Inner Choroiditis
Section outline
-
-
Description
Multimodal imaging of a young myopic patient with punctate inner choroidopathy (PIC) and secondary choroidal neovascularization (CNV).
Uploaded on: 10/28/2025